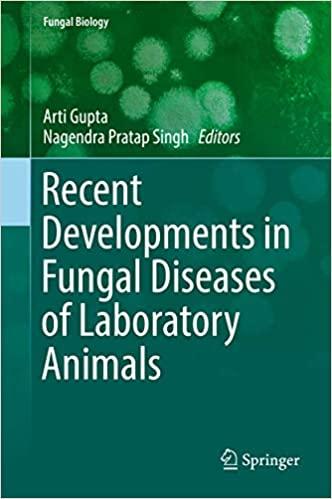
thumbnail

Latest 100 Movies
Trending 10 in all category
4K Movies
Remux 4K Movies
1080p Movies
Remux 1080p Movies
720p Movies
480p Movies
x265 Movies
Remux x265 Movies
x264 Movies
Remux BluRay Movies
BluRay Movies
60FPS
Trending 100 Movies
4K ITA Movies
ITA 1080p Movies
ITA 720p Movies
ITA 480p Movies
EvilAngel XXX
26 04 07 XXX
TonightsGirlfriend XXX
blacked XXX
TushyRaw XXX
Vixen XXX
Trending 100 XXX
4K XXX
1080p XXX
720p XXX
480p XXX
x265 XXX
x264 XXX
WWE TV Show
UFC TV Show
4K TV
1080p TV
720p TV
480p TV
x265 TV
x264 TV
BluRay TV
Trending 100 TV
FLAC Quality Music
320kbps Music
POP Music
Trending 100 Music
Quick Filters:
| C. | File | Category | Added | Time Since | Size | S. | L. |
|---|---|---|---|---|---|---|---|
|
|
Other |
2023-10-28
|
2 years, 5 months
|
931.3 KB | 0 | 0 | |
|
|
Other |
2023-10-28
|
2 years, 5 months
|
29.9 MB | 0 | 0 | |
|
|
Other |
2023-10-28
|
2 years, 5 months
|
847.6 KB | 0 | 0 | |
|
|
Other |
2023-10-28
|
2 years, 5 months
|
834.3 KB | 0 | 0 | |
|
|
Other |
2023-10-28
|
2 years, 5 months
|
908.2 KB | 0 | 0 | |
|
|
Other |
2023-10-28
|
2 years, 5 months
|
91.6 MB | 0 | 0 | |
|
|
Other |
2023-10-28
|
2 years, 5 months
|
12.6 MB | 8 | 1 | |
|
|
Other |
2023-10-28
|
2 years, 5 months
|
10.0 MB | 22 | 21 | |
|
|
Other |
2023-10-28
|
2 years, 5 months
|
14.6 MB | 40 | 50 | |
|
|
TV |
2023-10-28
|
2 years, 5 months
|
1.0 GB | 0 | 0 | |
|
|
TV |
2023-10-28
|
2 years, 5 months
|
348.5 MB | 0 | 0 | |
|
|
Other |
2023-10-28
|
2 years, 5 months
|
846.7 KB | 0 | 0 | |
|
|
Other |
2023-10-28
|
2 years, 5 months
|
38.9 MB | 0 | 0 | |
|
|
Other |
2023-10-28
|
2 years, 5 months
|
41.4 MB | 0 | 4 | |
|
|
Other |
2023-10-28
|
2 years, 5 months
|
690.6 MB | 20 | 28 | |
|
|
Other |
2023-10-28
|
2 years, 5 months
|
1.6 MB | 0 | 0 | |
|
|
Other |
2023-10-28
|
2 years, 5 months
|
5.2 MB | 0 | 0 | |
|
|
Other |
2023-10-28
|
2 years, 5 months
|
2.7 MB | 0 | 0 | |
|
|
Other |
2023-10-28
|
2 years, 5 months
|
27.7 MB | 0 | 3 | |
|
|
Other |
2023-10-28
|
2 years, 5 months
|
9.0 MB | 0 | 0 | |
|
|
Other |
2023-10-28
|
2 years, 5 months
|
23.9 MB | 0 | 6 | |
|
|
Other |
2023-10-28
|
2 years, 5 months
|
3.2 MB | 0 | 1 | |
|
|
TV |
2023-10-27
|
2 years, 5 months
|
362.7 MB | 0 | 1 | |
|
|
TV |
2023-10-27
|
2 years, 5 months
|
1.2 GB | 0 | 3 | |
|
|
TV |
2023-10-27
|
2 years, 5 months
|
825.1 MB | 0 | 0 | |
|
|
TV |
2023-10-27
|
2 years, 5 months
|
601.9 MB | 0 | 0 | |
|
|
Other |
2023-10-27
|
2 years, 5 months
|
84.4 MB | 47 | 28 | |
|
|
Other |
2023-10-27
|
2 years, 5 months
|
85.2 MB | 0 | 0 | |
|
|
Other |
2023-10-27
|
2 years, 5 months
|
6.9 MB | 0 | 0 | |
|
|
Other |
2023-10-27
|
2 years, 5 months
|
3.2 MB | 0 | 0 | |
|
|
TV |
2023-10-27
|
2 years, 5 months
|
1.0 GB | 0 | 0 | |
|
|
TV |
2023-10-27
|
2 years, 5 months
|
171.4 MB | 0 | 0 | |
|
|
TV |
2023-10-27
|
2 years, 5 months
|
1.6 GB | 0 | 0 | |
|
|
TV |
2023-10-27
|
2 years, 5 months
|
1.5 GB | 0 | 0 | |
|
|
Other |
2023-10-27
|
2 years, 5 months
|
24.6 MB | 0 | 0 | |
|
|
Other |
2023-10-27
|
2 years, 5 months
|
44.8 MB | 0 | 0 | |
|
|
Other |
2023-10-27
|
2 years, 5 months
|
5.5 MB | 31 | 10 | |
|
|
Other |
2023-10-27
|
2 years, 5 months
|
65.4 MB | 31 | 15 | |
|
|
TV |
2023-10-27
|
2 years, 5 months
|
172.8 MB | 26 | 16 | |
|
|
TV |
2023-10-27
|
2 years, 5 months
|
1.0 GB | 16 | 16 | |
|
|
TV |
2023-10-27
|
2 years, 5 months
|
348.4 MB | 36 | 30 | |
|
|
TV |
2023-10-27
|
2 years, 5 months
|
1.5 GB | 41 | 27 | |
|
|
TV |
2023-10-27
|
2 years, 5 months
|
506.5 MB | 11 | 18 | |
|
|
TV |
2023-10-27
|
2 years, 5 months
|
1.6 GB | 48 | 11 | |
|
|
TV |
2023-10-27
|
2 years, 5 months
|
348.4 MB | 13 | 11 | |
|
|
TV |
2023-10-27
|
2 years, 5 months
|
1.1 GB | 25 | 27 | |
|
|
TV |
2023-10-27
|
2 years, 5 months
|
264.0 MB | 33 | 32 | |
|
|
Other |
2023-10-27
|
2 years, 5 months
|
1.6 GB | 0 | 9 | |
|
|
Other |
2023-10-27
|
2 years, 5 months
|
3.6 MB | 0 | 0 | |
|
|
TV |
2023-10-27
|
2 years, 5 months
|
1.5 GB | 0 | 0 |
Do you mean to search user:Labou